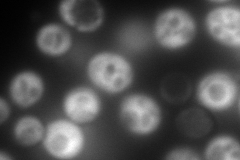
YGR285C
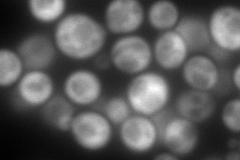
YGR285C
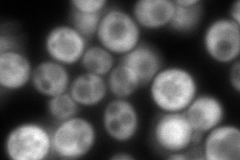
YGR285C
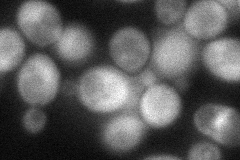
YGR285C
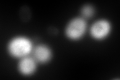
YGR285C
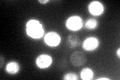
YGR285C

View description
Cytosolic ribosome-associated chaperone that acts, together with Ssz1p and the Ssb proteins, as a chaperone for nascent polypeptide chains; contains a DnaJ domain and functions as a J-protein partner for Ssb1p and Ssb2p
Localization:
Intensity:
Fold change:
Significance:
-
C’ GFP library in SD

cytosol503.1 -
N' NOP1pr-GFP in SD
cytosol502.019 -
N' TEF2pr-mCherry in SD
cytosol379.591 -
N' NATIVEpr-GFP in SD
cytosol334.737 -
N' TEF2pr-VC and Cyto-VN in SD
cytosol67.2807 -
C’ GFP library in SD+DTT
cytosol619.951.23No -
C’ GFP library in SD+H2O2

cytosol619.951.23No -
C’ GFP library in Starvation Media
cytosol352.550.7No -
C’ GFP library on the background of Pup2-DaMP

cytosol -
C’ GFP library on the background of CCT mutant

cytosol460.5230.915363No
